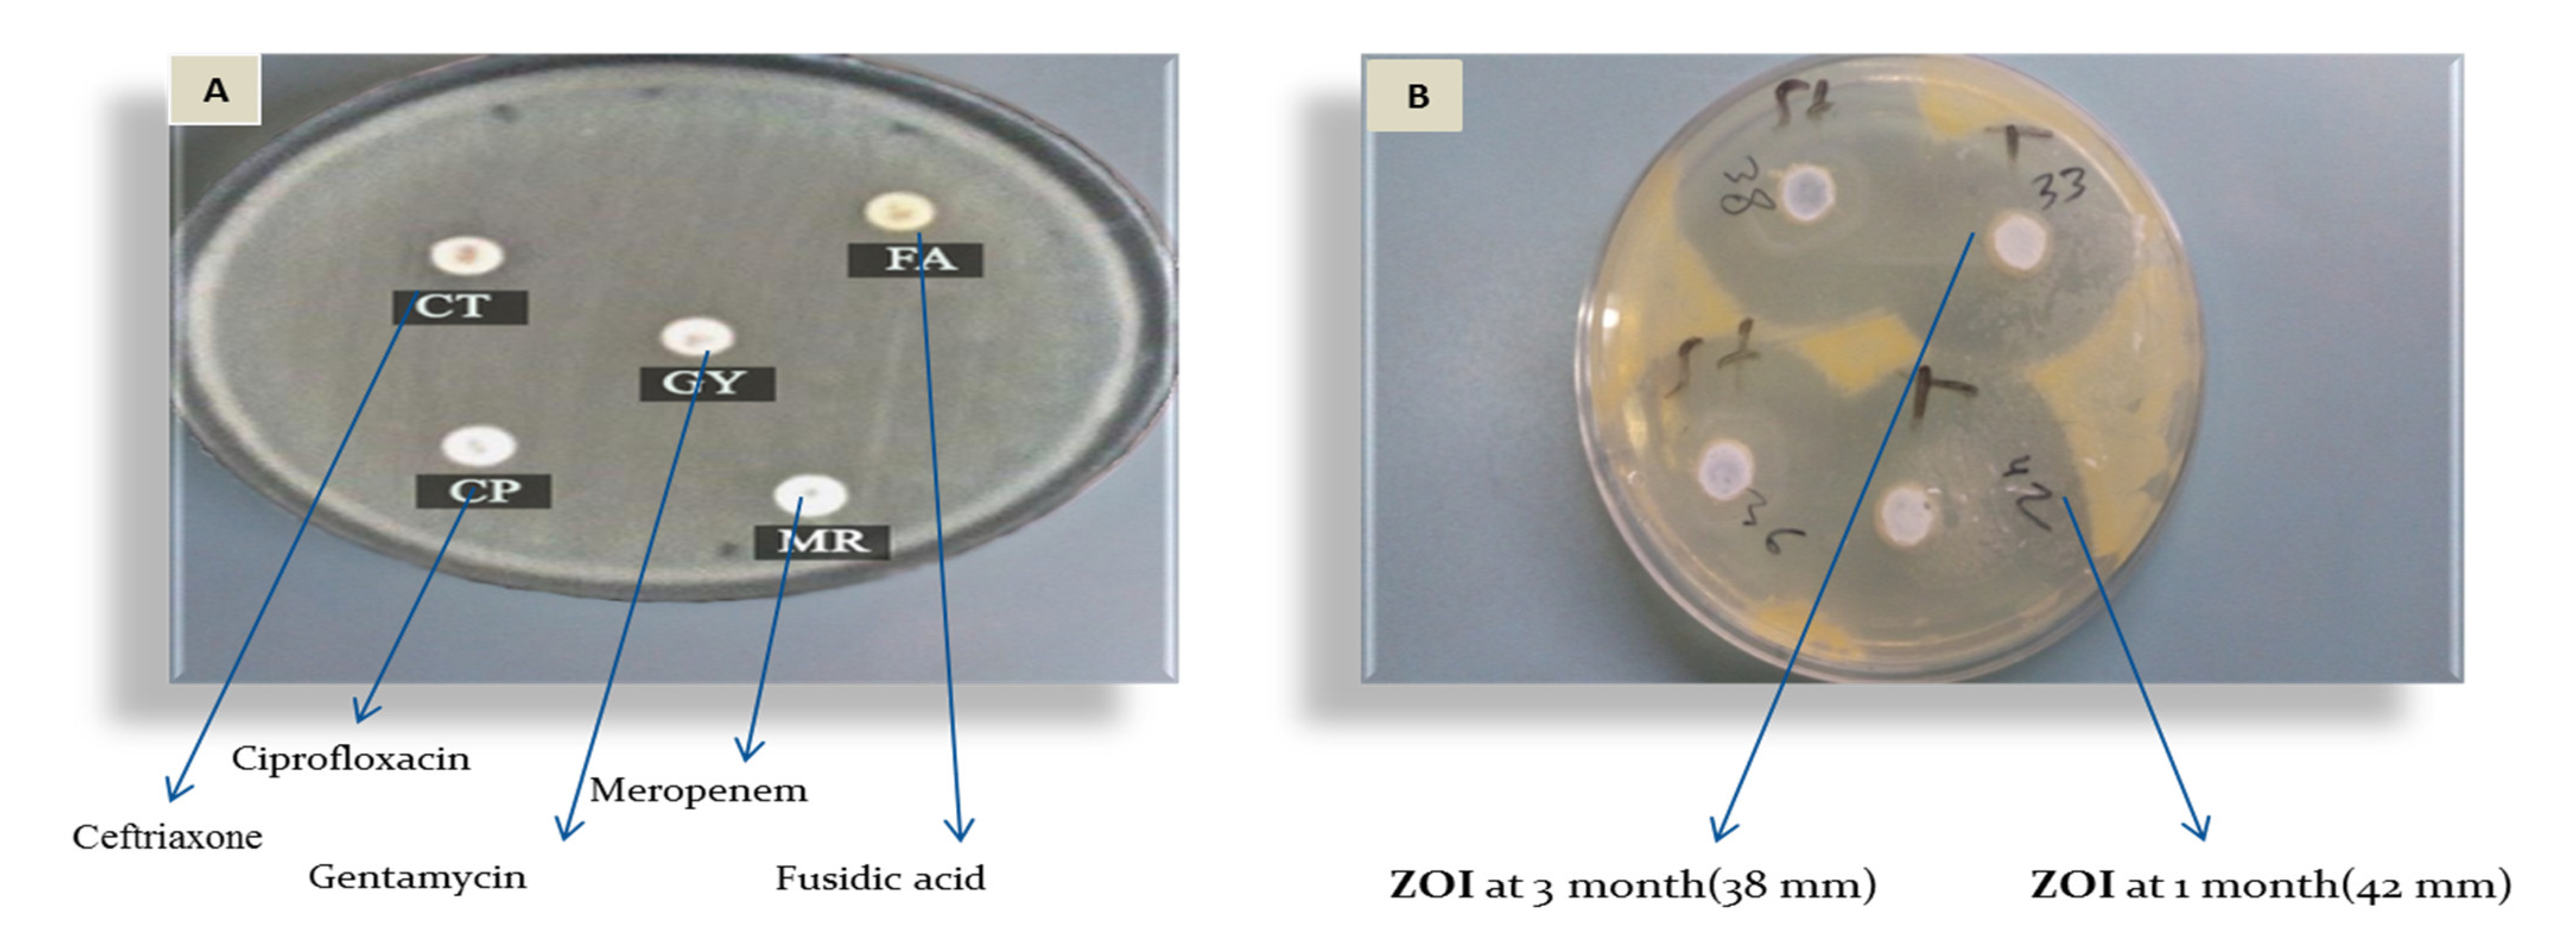
Pharmaceutics 14 01638 g004 550

1. Introduction
Creams are the most commonly used pharmaceutical preparations available for dermatological uses [
1]. Creams have been described as semi-solid emulsions or emulsions of elevated viscosity produced for topical application [
2,
3,
4]. The recent classification and definition of creams define them as semi-solid dosage forms consisting of more than 20% water or volatile components (hydrocarbons) and about 50% wax or polyethylene glycol as a vehicle for exterior skin application [
5]. Pharmaceutical creams may contain one or more active pharmaceutical ingredients (APIs) dispersed in oil in water (O/W) or water in oil (W/O) systems. Different physicochemical destabilizing processes that depend on time and temperature have been used to describe the physical instability of creams. These processes are coalescence, creaming, flocculation, phase inversion, sedimentation, and Ostwald ripening [
6].
Fusidic acid is an effective antibiotic used to treat many infections caused by methicillin-resistant Staphylococcus aureus (MRSA) and methicillin-susceptible Staphylococcus aureus (MSSA) [
7]. Fusidic acid has a narrow spectrum of bacteriostatic antibiotic activity and has been used clinically since the 1960s [
8]. Fusidic acid inhibits bacterial protein synthesis by binding to elongation factor G (EF-G) on the ribosomes and, therefore, prevents nascent polypeptides’ elongation [
9]. Fusidic acid resistance in
S. aureus usually develops by altering or protecting the drug target; these mechanisms have different underlying molecular mechanisms [
10]. Reports from various geographical areas worldwide have revealed that the prevalence of resistance of
S. aureus strains to fusidic acid has remained low in recent years [
11,
12,
13]. Natural products and several ions have been used to overcome multidrug resistance in bacteria [
14,
15,
16].
Copper sulfate pentahydrate (CuSO
4·5H
2O) and zinc sulfate heptahydrate USP (ZnSO
4·7H
2O) are used in many topical formulations owing to their antibacterial and antiviral activities [
17]. Furthermore, evidence suggests that copper can inhibit some pathogens, including MRSA, influenza virus, Pseudomonas species [
18,
19,
20], and
E. coli [
21]. The proposed mechanism of action of copper sulfate includes binding to protein molecules and denaturation of DNA; furthermore, it produces free radicals that damage the cell integrity and inhibit enzymes necessary for the vital functions of bacteria [
22,
23].
Zinc has been used as a single ingredient in topical products or in combination with other components due to its protective skin effects against inflammation and dermatological infections. These activities are due to the inhibition of macrophages, neutrophils, and inflammatory cytokines [
24]. In addition, zinc is necessary for microbial cellular construction, metabolism, DNA and protein synthesis, and wound healing [
25].
The possibility of the synergistic effects of zinc and copper against
E. coli and
S. aureus has been evaluated and showed significant activity at different concentrations. The 3% combination of zinc and copper has superior antimicrobial activity on the tested organisms [
26,
27]. However, these ions’ high reactivity and incorporation often create a formulation challenge. In addition, the oxidation reaction catalysis leads to some changes, including changes in efficacy, physical and/or chemical instability, the shelf-life of formulations, odor formation, and color and quality change [
28]. Therefore, the stability of the product and the antibacterial activity were studied for 12 weeks at two different temperatures.
In Palestine, there is a lack of studies regarding the prevalence of fusidic acid resistance among clinical isolates of S. aureus (FRSA). However, a few reports indicate increased fusidic acid use, particularly in recurrent topical infections caused by S. aureus. Therefore, the current investigation aims to develop and evaluate the synergistic efficacy of fusidic acid in combinations with natural products, including oleuropein, thyme oil, zinc sulfate, and copper sulfate, in a cream formulation to eradicate fusidic-acid-resistant microorganisms in skin infections.
2. Materials and Methods
2.1. Materials
All materials used in this research met the purity requirements for pharmaceutical and analytical grades. The materials were donated by Beit-Jala Pharmaceutical Co., Ltd. Bethlehem, Palestine, including fusidic acid, zinc sulfate, copper sulfate, oleuropein, thyme oil, cetostearyl alcohol, macrogol, A6 macrogol A25, paraffin oil, propylene glycol, and Fucidin TM.
2.2. Methods
2.2.1. Formulation of the Topical Cream
The cream base excipients were selected based on the marketed product Zydex TM (Beit-Jala Pharmaceutical Co., Ltd., Bethlehem, Palestine). The formulations were prepared using a hot emulsification method, where the oily and aqueous phases were melted separately at (60 °C and 70 °C, respectively) and then mixed. The oil phase consists of cetostearyl alcohol, macrogol A6 and A25, thyme oil, and paraffin oil with dispersed oleuropein. The concentrations of thyme oil and oleuropein were determined based on a previous study carried out in our lab and published elsewhere [
29]; these substances showed effectiveness against selected microorganisms [
29]. The aqueous phase consists of purified water, fusidic acid, zinc sulfate, copper sulfate, and propylene glycol. The final formulation was prepared as follows: the oil phase was slowly added to the aqueous phase and mixed with a vertical mixer for 5 min, followed by stirring using a stirrer until reaching a temperature of 40 °C. After extensive experimental trials, three formulations (F1, F2, F3) of 500 g were prepared. The composition of the formulations is shown in
Table 1. All formulations were placed in plastic containers and stored for further evaluation.
2.2.2. In Vitro Antibacterial Activity
The antimicrobial activity of the formulas was determined using the agar diffusion method, and the zoon inhibition diameter was measured. Each prepared formula was tested in triplicate. The microorganisms tested (
E. coli ATCC 8739,
S. aureus ATCC 6538, FRSA) were cultured on sterile tryptic soy agar plates. The inoculum suspension equivalent to a 0.5 McFarland standard was prepared from an overnight culture and then diluted 1:100 in MH broth according to the guidelines of the Clinical Laboratory Standards Institute (CLSI) [
30]. An aliquot of 100 µL was placed on the surface of MH agar plates and then spread by a sterile glass rod. The plates were then left for 15 min to absorb the inoculum. A sterile cork borer was used to make wells of 5 mm in diameter by punching the inoculated MH agar plates. The cut agar was removed from the wells using a sterile needle. An aliquot of 0.2 mL of the samples and their dilutions was incubated at 37 °C for three days. The formulation with the minor concentration of excipients that gave the best antibacterial effects was selected as the optimal formulation for further testing in the topical cream.
2.3. Chemical and Physical Evaluation of the Optimal Formulation (F2)
2.3.1. Determination of Oleuropein by HPLC
Phosphate buffer (pH 3.0) was prepared by mixing equal volumes of 0.01M phosphoric acid and 0.01 M monobasic sodium phosphate. The mobile phase was prepared by filtering and degassing a mixture (20:80) of acetonitrile and phosphate buffer (pH 3.0). The mobile phase also contains 1% acetic acid. The test solution was prepared by mixing 70 mg of oleuropein dissolved in a mixture of acetonitrile and water (20:80) in 100 mL volumetric flasks [
31]. High-performance liquid chromatography (HPLC) equipped with a 280 nm detector and silica-based C18 bonded phase column C18, 5 μm (5 μm, 150 × 4.6 mm inner diameter) was used. The flow rate was 1.0 mL/min, and the injection volume was 20.0 μL.
2.3.2. Determination of Fusidic Acid by HPLC
Phosphate buffer (pH 3.5) was prepared by mixing equal volumes of 0.01 M phosphoric acid and 0.01 M monobasic sodium phosphate. The mobile phase was prepared by filtering and degassing a mixture of methanol, 1.0 g potassium dihydrogen phosphate dissolved in 500 mL purified water, and a mixture of phosphoric acid with acetonitrile pH 3.5 (20:45:35). The test solution was prepared by dissolving 40 mg of fusidic acid in a diluent of ethanol and purified water (70:30) in a 200 mL volumetric flask. This process was performed using high-performance liquid chromatography (HPLC) equipped with a 235 nm detector and Lichrosphere RP-select B, 5μm (125 × 4 mm). The flow rate was 1.5 mL/min, and the injection volume was (20 μL).
2.3.3. Determination of Zinc Sulfate Heptahydrate and Copper Sulfate Pentahydrate
Determination of the assay for (ZnSO4·7H2O) and (CuSO4·5H2O) was prepared by a complex metric titration method because of the unavailability of ICP-MS for the analysis of trace elements. The percent content was calculated by the equation: ions % = TS × C1 × C2 × 100/C3, where: TS: titration consumption in ml, C1: corresponds to ions in mg/mL (0.1 mol/L × molar mass g/mol) C2: titer EDTA (dimensionless unit), C3: sample weight in mg. The titration was conducted with 0.1 M EDTA to achieve the green endpoint at accelerated conditions (40 ± 2 °C/75% ± 5% RH) [
32]. Once the green endpoint was achieved, a half a milligram (0.5 mg) of the F2 formula was mixed with 100 mL purified water, 1 mL of concentrated acetic acid, 2.5 mg of xylenol orange, and a sufficient amount of a hexamine mixture ratio of 1:2 in a 250 mL volumetric flask.
2.3.4. Determination of Viscosity
The viscosity of the finished product (fusidic acid cream) was determined in triplicate using the Brookfield IV viscometer # (QCA-036): Spindle # 4, 30 rpm, 50 mL beaker at a temperature of 22 °C. The readings were taken after 3 min [
33].
2.3.5. Organoleptic Characteristics
All formulations were observed visually for their texture, color, homogeneity, and phase separation. After two minutes of skin application, the feel test was performed. In accordance with the procedure described by Tchienou, the spreadability test was performed on samples in triplicate at zero time, one month, and three months at 25 °C and under accelerated conditions (40 °C/75% 5% RH) [
34]. The spreadability of the creams was determined by measuring the spreading diameter of 1 g of the sample placed between two horizontal glass plates measuring 10 cm × 20 cm after one minute
where:
m: weight tied on the upper slide, l: length of the glass slide, t: time in s.
2.3.6. Minimal Inhibitory Concentrations for the Selected Novel Topical Cream F2 and Individual Active Substances
The broth microdilution method evaluated the susceptibility of FRSA to the selected formula. It was performed on sterile microtiter plates. The inoculum density was set to 0.5 McFarland, diluted 10-fold in sterile saline, and 5 μL of this suspension was inoculated into 0.1 mL of CAMHB-cation-adjusted Mueller–Hinton broth to reach the final inoculum of 5 × 104 cfu/well. The novel topical cream was diluted in DMSO and added to CAMHB from 2560 μg/mL to 1.25 μg/mL by two-fold dilution in 96-well microtiter plates. After inoculation, plates were incubated at 36 °C for 24 h. The MIC was determined as the lowest antimicrobial agent concentration that inhibits the visible growth of a microorganism in the broth dilution susceptibility test from the wells without visible growth. Ten microliters in CAMHA were cultured and incubated at 36 °C for 24 h [
17,
35].
Serial dilutions for each formulation were prepared in the diagnostic sensitivity test (DST) for the following microbes: Candida albicans (ATCC # 10231), Escherichia coli (ATCC # 8739), Pseudomonas aeruginosa (ATCC # 9027), Staphylococcus aureus (ATCC # 6538). All dilutions were made with freshly prepared autoclaved agar cooled to a temperature of 47–50 °C in an oven before adding a formulation.
The MIC was determined for the cream formulation by the agar dilution assay against FRSA strains to 1 × 105 CFU to prepare the inoculums. A sample of 0.5 g from the formula in a final volume of 50 mL agar was prepared. Further serial dilutions with agar were performed from this solution to obtain a 0.5–0.0001% concentration. The lowest concentration of formula that prevented bacterial growth is considered the MIC of the formula for all pathogens. The F2 formula and the individual active ingredients (fusidic acid, zinc sulfate, copper sulfate, oleuropein, and thyme oil) were evaluated for the MIC.
2.3.7. Stability Studies
The three formulations (F1, F2, and F3) were stored at accelerated conditions (40 ± 2 °C/75% ± 5% RH). At zero time, one month, and three months, they were evaluated to determine their antibacterial activity and physical stability (appearance and spreadability). The formula with the optimal antibacterial activity and physical stability was selected for further evaluation.
The final optimal formulation (F2) was stored at 25 °C and 40 °C and evaluated after three months for its physicochemical stability. The viscosity of the formula was determined every month over three months. In addition, the formula and FucidinTM were tested for antibacterial activity against Candida albicans (ATCC # 10231), Aspergillus niger (ATCC # 16404), Escherichia coli (ATCC # 8739), Pseudomonas aeruginosa (ATCC # 9027), and Staphylococcus aureus (ATCC # 6538) by the agar well diffusion assay over a three-month period at 25 °C and 40 °C.
3. Results
In this study, three different cream formulations were developed (
Table 1). All formulations were divided into three aliquots, as shown in
Table 2, to evaluate their antibacterial activity and physical stability at accelerated conditions (40 ± 2 °C/75% ± 5% RH). In addition, fusidic acid cream from the local market (Fucidin TM), as a control, was stored under the same conditions and evaluated. The mean (
n = 3) of the zone of inhibition for microorganism strains for each formulation is shown in
Table 2. The in vitro antibacterial activity was determined by measuring the diameter of the zone of inhibition on the agar plate for bacteria, yeast, and FRSA samples. According to the Clinical Laboratory Standards Institute (CLSI) guidelines, the acceptable reported quality control limits for
S. aureus and
E. coli are 19–27 mm and 19–26 mm.
The results revealed that formula F1 did not appear to have a desirable antibacterial activity against
E. coli. No inhibition zones were observed on the agar plates with FRSA samples; therefore, they were discontinued from further evaluation for this formula. The results also showed that trade cream Fucidin TM has limited antimicrobial activity against
S. aureus; at the same time, it did not have antibacterial activity against
E. coli and FRSA (
Table 2).
The F2 and F3 formulas, which contain higher quantities of oleuropein, zinc sulfate, and copper sulfate than F1, showed desirable antibacterial activity with distinct zones of inhibition observed on the agar plates. Furthermore, the inhibition zones increased as the concentration of oleuropein, zinc sulfate, and copper sulfate increased, indicating concentration-dependent antimicrobial activity for eradicating S. aureus, E. coli, and FRSA.
The two cream formulations (F2 and F3) showed antibacterial activity. The F3 formula was shown to have a slightly greater measurement for the diameter of the zone of inhibition despite having higher amounts of oleuropein, zinc sulfate, and copper sulfate than F2. However, the physical appearance of the F3 formula was unacceptable. Formula F3 was bold blue–greenish in nature, the color formed due to increasing the concentration of oleuropein and copper sulfate. Additionally, at 30 rpm, the viscosities for the cream formulations were observed to be 151,601.25 cps for F2, 184,501.05 cps for F3, and the targeted viscosity was to be comparable to fucidin TM’s viscosity (145,501.05 cps). Higher viscosity values might negatively impact the rate of drug released from the formulation vehicle, which would decrease the amount of drug that is available for skin penetration. On the other hand, formula F2 exhibited better spreadability than formula F3. The F2 formula displayed attractive physical characteristics, viscosity, and desirable antibacterial activity; hence, it was selected as the topical cream formula for further studies and preparation for this project.
3.1. Physicochemical Properties Evaluations
The physicochemical properties of formula F2 were investigated for three months at 25 °C and 40 °C. The results indicated an excellent appearance and homogeneity for the cream formulation (
Table 3). The physical appearance of the cream formulation was light green, matching the natural color obtained from Oleuropine and copper sulfate. The smell of thyme was present in the formulation. In addition, the texture of the cream was smooth with no phase separation. Furthermore, the physicochemical properties of the F2 formula at both conditions remained relatively similar.
3.2. Spreadability Test
The spreadability of the cream formulations is directly related to the efficacy of the topical treatment, which predicates the patient spreading the semi-solid formulation in an even layer to manage a standard dose [
36].
The values in
Figure 1 illustrate the spreading diameter after one minute. The spreadability diameter indicates the range of the area to which the formulation easily expands upon skin application by a small amount of shear [
37]. No apparent change in spreadability was observed with increased storage conditions from 25 °C to 40 °C (
n = 3). The mean ± standard deviation of spreadability for the F2 samples at different conditions ranged from 23.5 ± 0.25 g·cm/s to 23.48 ± 0.3 g·cm/s. The results showed that formula F2 is more likely to have better spreadability than trade products.
3.3. HLPC Analysis of Fusidic Acid and Oleuropein
By testing the percentage of fusidic acid and oleuropein by HPLC in the F2 cream, the results showed that the assay of oleuropein was very close in both conditions, 25 °C and 40 °C. Oleuropein in both conditions decreased by about 3% after three months of storage.
A similar result was obtained for fusidic acid after three months of storage at 25 °C and 40 °C, where the assay ranged from 102% at zero days and decreased to 99% and 98% after one and three months of storage, respectively, as shown in
Table 4. These results indicate that both fusidic acid and oleuropein are stable and there is no interaction with the other ingredients in the formula of F2.
3.4. Determination of Zinc Sulfate and Copper Sulfate
The zinc sulfate and copper sulfate quantities in formulation F2 were analyzed at zero and after three months (
Table 5). After achieving the green endpoint, it was noticed that a somewhat low percent of content was obtained from the EDTA titration analysis from zero to the third month, which decreased from 99.8 to 96.2% for zinc sulfate and from 98.7 to 93.4% for copper sulfate at 25 °C. Relatively similar results were obtained at 40 °C, where the assay decreased from 99.3 to 95.4% for zinc sulfate and from 98.5 to 92% for copper sulfate from zero time to the third month. One of the reasons for such a decreased percent of element content might be simple interaction with cetostearyl alcohol with metal salts. However, in this formula, this incompatibility was relatively minor. Furthermore, diluting the sample solution with ethanol in a 1:1 ratio can avoid high temperatures to titrate. The results in this study were better than previous research projects conducted using ICP-MS analysis. A relatively low percentage of metal ions was obtained between 24% for copper and 21% for zinc [
27].
3.5. Viscosity Measurement
The viscosities of the F2 formula and FucidinTM were determined, and the results are shown in
Figure 2. The viscosity for F2 at 30 rpm was found to be 15,160 ± 1.25 cps, while Fucidin TM was found to be 14,550 ± 1.05 cps, which are within the acceptable limits [
24]. The viscosity decreased over shear stress, and it was clearly explained that the viscosity of F2 at 0 time and 3 months at 40 °C was found within acceptable limits. It is supposed that a non-Newtonian behavior with the pseudoplastic flow was seen in both formulas. It is evident from
Figure 2 that as the rpm or shear stress increased, the viscosity decreased in both formulations. In conclusion, the resistance to flow of FucidinTM was low compared to F2 by pouring the formulations out of the container.
3.6. Determination of the MICs for Cream Formulations, Their Active Substances, and FRSA Sample
Fusidic acid is primarily active against gram-positive bacteria such as
Staphylococcus spp., with no activity against
E. coli,
P. aeruginous, and
C. albicans, the same as the results shown with Fucidin TM (Control), reflecting the growth of the microorganisms tested on agar plates, except for staphylococci. Interestingly, the F2 formula has broad antimicrobial activity in vitro; it was highly active against all microbes by inhibiting the growth of all pathogens as compared with fucidinTM; see
Figure 3A–E after storage at accelerated conditions (40 ± 2 °C/75% ± 5% RH) at zero time only.
Parallel with the above test, the F2 formula was evaluated to test its antibacterial activity against FRSA colonies. Twenty-three FRSA isolates were collected from Palestinian hospitals (Beit-Jala Governmental Hospital, Istishari Hospital, Bethlehem Arab Society for Rehabilitation (BASR), and Surgery and Caritas Baby Hospital (CBH)) between January and October 2018. All clinical isolates (FRSA) were susceptible to the F2 formula, with a zone of inhibition greater than 19 mm. One of the FARS isolates (
Figure 4A) was obtained from a breast cancer and nodular melanoma patient. It was resistant to ceftriaxone (CT), fusidic acid (FA), gentamycin (GM), ciprofloxacin (CP), and meropenem (MR). However, as shown in
Figure 4B, the F2 formula showed antibacterial activity against the FRSA isolate.
There were no zones of inhibition observed on the agar plates with fucidinTM in the FRSA samples (
Figure 4A), but the zone of inhibition increased in the F2 (
Figure 4B) plate to an average of 37.25 mm from the first to the third month.
After storing the F2 formula for one month at accelerated conditions (40 ± 2 °C/75% ± 5% RH), the MICs of the formula F2 were as presented in
Table 6. In addition, the results of the MIC of each active ingredient are shown in
Table 6.
Our results demonstrated potent activity against S. aureus and E. coli. (MIC 10.5 µg/mL for EC (F2) as the entire cream or fusidic acid alone as part of the cream). However, there was also an effect on C. albicans and P. aurginosa (MIC 85 µg/mL for the entire cream). Furthermore, our additives (oleuropein, thyme oil, copper sulfate, and zinc sulfate) showed moderately effective activity against the pathogen strains with specific MIC values.
3.7. Stability of Formula F2
The formulation F2 was stored at 25 °C and under accelerated conditions (40 ± 2 °C/75% ± 5% RH) for three months in plastic containers (
n = 3). The results showed that F2 was stable after three months under both conditions. There was no precipitation and no change in appearance, color, or pH (
Table 7). The fusidic acid, oleuropein, and zinc sulfate assays were within the acceptable range. The assay of copper sulfate was decreased by about 6.5% after three months of storage at both conditions. The formula was evaluated for antibacterial activity after three months of storage. As shown in
Table 8, the F2 cream has an antibacterial activity where the observed inhibition zones were above 19 cm.
4. Discussion
The emergence of antimicrobial resistance to currently available antibiotics is a significant worldwide problem. Designing new agents or methods to overcome resistance has been performed by either increasing the antimicrobial dosage or combining agents with a different mechanism of action. Metal ions have antimicrobial potential and have been used since long ago; furthermore, metals have a synergistic activity when combined with other antimicrobial agents to overcome multidrug-resistant pathogens, which has been the focus of research currently in treating infections [
16,
38]. Fusidic acid is a narrow-spectrum bacteriostatic steroid antibiotic commonly used to treat infections caused by MRSA. Resistance to fusidic acid due to prolonged use is mediated by the FusB family of proteins. The FusB protein binds to elongation factor G (EF-G) and promotes dissociation of the antibiotic from its target, restoring normal protein synthesis to proceed uninterrupted [
39]. High rates of antibiotic resistance of
S. aureus to Fusidic acid have been associated with increased usage and prolonged therapy. The prevalence of
S. aureus resistance to fusidic acid was reported as 10.7% in some studies. The highest resistance to fusidic acid has been reported in Greece at a rate of 62.4% [
40]. This study formulated a cream containing metal ions complexed with fusidic acid, oleuropein, and thyme oil with antimicrobial activity against tested microorganisms, including
S. aureus,
E. coli,
P. aeruginosa,
C. albicans, and
A. niger.
The formula developed in this study was developed without adding chemical preservatives. Instead, the novel formulation was developed by incorporating natural medicinal products (oleuropein and thyme oil) with significant antibacterial effects [
29]. Several investigations found that the EO of thyme has considerable antibacterial action against bacteria and most of the fungal species studied by these authors. In contrast, the extract only had moderate antimicrobial activity against bacteria and was ineffective against fungus [
39].
Furthermore, metal ions, copper sulfate, and zinc sulfate, which were studied as antibacterial agents in previous research, had a synergistic antibacterial activity with fusidic acid against
Staphylococcus aureus and
E. coli [
40]. Other studies showed that using copper to prevent nosocomial infections is promising. It has been reported that the growth of all drug-resistant Gram-negative clinical isolates, including K. pneumoniae and
E. coli, and
S. aureus have been significantly inhibited at 1600 µg/mL of copper [
41].
In this study, two metal ions were used; copper and zinc showed enhanced antimicrobial activity. In the present research, formula F1 with a low concentration of oleuropein, zinc sulfate, and copper sulfate (
Table 2) did not appear to have desirable antibacterial activity against
E. coli, whereas an increase in the concentrations of these ingredients (F2) had significant antibacterial activity. Furthermore, the results revealed that the inhibition zones increased as the concentration of oleuropein, thyme oil, zinc sulfate, and copper sulfate increased. This showed that the activity of oleuropein, thyme oil, zinc sulfate, and copper sulfate against
S. aureus,
E.coli, and FRSA is directly related to their concentrations.
Regarding the preservative effectiveness, formula F2 was observed to have a similar diameter to the zone of inhibition on the agar plate. This work evaluated the lowest concentrations of excipients that could give the best antibacterial effect as a preservative.
From the results in
Table 2, the physical appearance of formula F3was unacceptable, which was bold blue–greenish in nature. The color formed due to increasing the concentration of oleuropein and copper sulfate. On the other hand, it was found that formula F2 exhibited better spreadability than formula F3, as shown in
Table 2.
The desirable antibacterial activity was demonstrated by formulation F2, making it the appropriate choice to prepare the topical cream for the final formulation. Therefore, further studies are required for formula F2 only. For this purpose, samples from formula F2 were stored at room temperature (25) and under accelerated conditions (40 ± 2 °C/75% ± 5% RH). Furthermore, these samples were evaluated at zero time, one month, and after three months to assess their antibacterial activity and physical and chemical stability.
5. Conclusions
The combination of fusidic acid, metal ions, and natural preservatives in a topical cream possesses antibacterial and antifungal properties. The formulated product effectively eradicates multidrug-resistant Gram-negative bacteria, MSSA and FRSA. In addition, it has acceptable physical and chemical properties, stability after prolonged storage for three months at room temperature, and accelerated conditions (40 ± 2 °C/75% ± 5% RH). However, the absence of ex vivo permeation investigations on human stratum corneum was a limitation of the current study. Furthermore, this finding lays the foundation for future studies to uncover these compounds’ pharmacodynamic and kinetics properties.
Author Contributions
Conceptualization, H.N., Y.S., N.J., and A.D.A.; methodology, H.N., Y.S., M.Q., and A.K.R.; investigation, Y.S., M.S., and I.S.; resources, H.N., M.S., and I.S.; data curation, Y.S., I.S., and H.N.; writing—original draft preparation, Y.S., H.N., N.J., and M.F.; writing—review and editing, H.N., N.J., A.D.A., A.K.R., M.F., and M.Q.; supervision, H.N. and M.F.; project administration, H.N., and M.Q. All authors have read and agreed to the published version of the manuscript.
Funding
This research received no external funding.
Institutional Review Board Statement
Not applicable.
Informed Consent Statement
Not applicable.
Data Availability Statement
The data used to aid the outputs of this research are available from Hani Naseef (
hshtaya@birzeit.edu) upon request.
Acknowledgments
This research was supported by Beit-Jala Pharmaceutical Co., Ltd., Bethlehem, Palestine.
Conflicts of Interest
Author Mahmmoud Sbeih is an employee of Beit-Jala Pharmaceutical Co., Ltd. Remaining authors declare no conflict of interest.
List of Abbreviations
APIs: active pharmaceutical ingredients. ZOI: potential inhibition zone. FRSA: fusidic-acid-resistant Staphylococcus aureus. MRSA: methicillin-resistant Staphylococcus aureus. MSSA: methicillin-susceptible Staphylococcus aureus. EF-G: elongation factor G. CLSI: Clinical Laboratory Standards Institute.
References
- Walters, K.A. Dermatological and Transdermal Formulations; CRC Press: Boca Raton, FL, USA, 2002; p. 567. [Google Scholar]
- Maibach, H. Dermatological formulations: Percutaneous absorption. By Brian W. Barry. Marcel Dekker, 270 Madison Avenue, New York, NY 10016. 1983. 479 pp. 16 × 23.5cm. Price $55.00 (2070 higher outside the US. and Canada). J. Pharm. Sci. 1984, 73, 573. [Google Scholar] [CrossRef]
- Aulton, M.E. Aulton’s Pharmaceutics the Design and Manufacture of Medicines, 5th ed.; Kevin Taylor, M.A., Ed.; Elsevier: Amsterdam, The Netherlands, 2018; ISBN 9780702070051. [Google Scholar]
- Flynn, G.L. General Introduction and Conceptual Differentiation of Topical and Transdermal Drug Delivery Systems. In Topical Drug Bioavailability, Bioequivalence, and Penetration; Springer: Boston, MA, USA, 1993; pp. 369–391. [Google Scholar] [CrossRef]
- Buhse, L.; Kolinski, R.; Westenberger, B.; Wokovich, A.; Spencer, J.; Chen, C.W.; Turujman, S.; Gautam-Basak, M.; Kang, G.J.; Kibbe, A.; et al. Topical drug classification. Int. J. Pharm. 2005, 295, 101–112. [Google Scholar] [CrossRef] [PubMed]
- Allen, L.V.; McPherson, T.B. Ansel’s Pharmaceutical Dosage Forms and Drug Delivery Systems, 12th ed.; Lippincott Williams & Wilkin: Philadelphia, PA, USA, 2021; ISBN 978-1975171773. [Google Scholar]
- Whitby, M. Fusidic acid in the treatment of methicillin-resistant Staphylococcus aureus. Int. J. Antimicrob. Agents 1999, 12, S67–S71. [Google Scholar] [CrossRef]
- Godtfredsen, W.O.; Jahnsen, S.; Lorck, H.; Roholt, K.; Tybring, L. Fusidic Acid: A New Antibiotic. Nature 1962, 193, 987. [Google Scholar] [CrossRef] [PubMed]
- Chopra, I. Mechanisms of resistance to fusidic acid in Staphylococcus aureus. J. Gen. Microbiol. 1976, 96, 229–238. [Google Scholar] [CrossRef] [Green Version]
- Delgado, A.; Zaman, S.; Muthaiyan, A.; Nagarajan, V.; Elasri, M.O.; Wilkinson, B.J.; Gustafson, J.E. The fusidic acid stimulon of Staphylococcus aureus. J. Antimicrob. Chemother. 2008, 62, 1207–1214. [Google Scholar] [CrossRef] [Green Version]
- Peng, K.T.; Huang, T.Y.; Chiang, Y.C.; Hsu, Y.Y.; Chuang, F.Y.; Lee, C.W.; Chang, P.J. Comparison of Methicillin-Resistant Staphylococcus aureus Isolates from Cellulitis and from Osteomyelitis in a Taiwan Hospital, 2016–2018. J. Clin. Med. 2019, 8, 816. [Google Scholar] [CrossRef] [Green Version]
- Chen, H.J.; Hung, W.C.; Tseng, S.P.; Tsai, J.C.; Hsueh, P.R.; Teng, L.J. Fusidic acid resistance determinants in Staphylococcus aureus clinical isolates. Antimicrob. Agents Chemother. 2010, 54, 4985–4991. [Google Scholar] [CrossRef] [Green Version]
- Hamzah, A.M.C.; Yeo, C.C.; Puah, S.M.; Chua, K.H.; Chew, C.H. Staphylococcus aureus Infections in Malaysia: A Review of Antimicrobial Resistance and Characteristics of the Clinical Isolates, 1990–2017. Antibiotics 2019, 8, 128. [Google Scholar] [CrossRef] [Green Version]
- Rossiter, S.E.; Fletcher, M.H.; Wuest, W.M. Natural Products as Platforms to Overcome Antibiotic Resistance. Chem. Rev. 2017, 117, 12415–12474. [Google Scholar] [CrossRef]
- Areas, M.S.; Gonçalves, R.M.; Soman, J.M.; Souza Filho, R.C.; Gioria, R.; de Silva Junior, T.A.F.; Maringoni, A.C. Resistance of Xanthomonas euvesicatoria strains from Brazilian pepper to copper and zinc sulfates. An. Acad. Bras. Cienc. 2018, 90, 2375–2380. [Google Scholar] [CrossRef] [PubMed]
- Hobman, J.L.; Crossman, L.C. Bacterial antimicrobial metal ion resistance. J. Med. Microbiol. 2015, 64, 471–497. [Google Scholar] [CrossRef] [PubMed]
- Alsterholm, M.; Karami, N.; Faergemann, J. Antimicrobial activity of topical skin pharmaceuticals—An In vitro study. Acta Derm.-Venereol. 2010, 90, 239–245. [Google Scholar] [CrossRef] [PubMed] [Green Version]
- Grass, G.; Rensing, C.; Solioz, M. Metallic copper as an antimicrobial surface. Appl. Environ. Microbiol. 2011, 77, 1541–1547. [Google Scholar] [CrossRef] [Green Version]
- Weber, D.J.; Rutala, W.A. Self-Disinfecting Surfaces. Infect. Control Hosp. Epidemiol. 2012, 33, 10–13. [Google Scholar] [CrossRef]
- Rózańska, A.; Chmielarczyk, A.; Romaniszyn, D.; Majka, G.; Bulanda, M. Antimicrobial effect of copper alloys on Acinetobacter species isolated from infections and hospital environment. Antimicrob. Resist. Infect. Control 2018, 7, 1–8. [Google Scholar] [CrossRef]
- Faúndez, G.; Troncoso, M.; Navarrete, P.; Figueroa, G. Antimicrobial activity of copper surfaces against suspensions of Salmonella enterica and Campylobacter jejuni. BMC Microbiol. 2004, 4, 19. [Google Scholar] [CrossRef] [Green Version]
- Ibrahim, S.A.; Yang, H.; Seo, C.W. Antimicrobial activity of lactic acid and copper on growth of Salmonella and Escherichia coli O157:H7 in laboratory medium and carrot juice. Food Chem. 2008, 109, 137–143. [Google Scholar] [CrossRef]
- Sierra, M.; Sanhueza, A.; Alcántara, R.; Sánchez, G. Antimicrobial evaluation of copper sulfate (II) on strains of Enterococcus faecalis. In vitro study. J. Oral Res. 2013, 2, 114–118. [Google Scholar] [CrossRef] [Green Version]
- Topical Zinc Sulphate Solution for Treatment of Viral Warts—PubMed. Available online: https://pubmed.ncbi.nlm.nih.gov/17768472/ (accessed on 22 May 2022).
- Lansdown, A.B.G.; Mirastschijski, U.; Stubbs, N.; Scanlon, E.; Ågren, M.S. Zinc in wound healing: Theoretical, experimental, and clinical aspects. Wound Repair Regen. 2007, 15, 2–16. [Google Scholar] [CrossRef]
- Garza-Cervantes, J.A.; Chávez-Reyes, A.; Castillo, E.C.; García-Rivas, G.; Ortega-Rivera, O.A.; Salinas, E.; Ortiz-Martínez, M.; Gómez-Flores, S.L.; Peña-Martínez, J.A.; Pepi-Molina, A.; et al. Synergistic Antimicrobial Effects of Silver/Transition-metal Combinatorial Treatments. Sci. Rep. 2017, 7, 903. [Google Scholar] [CrossRef] [PubMed] [Green Version]
- Chen, M.X.; Alexander, K.S.; Baki, G. Formulation and Evaluation of Antibacterial Creams and Gels Containing Metal Ions for Topical Application. J. Pharm. 2016, 2016, 5754349. [Google Scholar] [CrossRef] [PubMed] [Green Version]
- Flora, S.J.S. Structural, chemical and biological aspects of antioxidants for strategies against metal and metalloid exposure. Oxidative Med. Cell. Longev. 2009, 2, 191–206. [Google Scholar] [CrossRef] [PubMed]
- Sahoury, Y.; Naseef, H.; Farraj, M.; Qurt, M.; El-Khairy, L. Antimicrobial activity of oleuropine and thyme extracts against selected pathogenic microorganisms and their potential uses as natural preservatives. Int. J. Pharm. Res. 2020, 13, 1088–1098. [Google Scholar] [CrossRef]
- M07: Dilution AST for Aerobically Grown Bacteria—CLSI. Available online: https://clsi.org/standards/products/microbiology/documents/m07/ (accessed on 9 July 2022).
- Al-Rimawi, F. Development and validation of a simple reversed-phase HPLC-UV method for determination of oleuropein in olive leaves. J. Food Drug Anal. 2014, 22, 285–289. [Google Scholar] [CrossRef] [PubMed] [Green Version]
- Panossian, Z.; Ferrari, J.V.; de Almeida, M.B. Determination of copper and zinc contents in brass plating solutions by titrimetric analysis: A review. Plat. Surf. Finish. 2004, 91, 38–43. [Google Scholar]
- United States Pharmacopeia. General Chapter, 〈3〉 Topical and Transdermal Drug Products—Product Quality Tests; USP-NF; United States Pharmacopeia: Rockville, MD, USA, 2022. [Google Scholar] [CrossRef]
- Djiobie Tchienou, G.E.; Tsatsop Tsague, R.K.; Mbam Pega, T.F.; Bama, V.; Bamseck, A.; Dongmo Sokeng, S.; Ngassoum, M.B. Multi-Response Optimization in the Formulation of a Topical Cream from Natural Ingredients. Cosmetics 2018, 5, 7. [Google Scholar] [CrossRef] [Green Version]
- Hammer, K.A.; Carson, C.F.; Riley, T.V. Antimicrobial activity of essential oils and other plant extracts. J. Appl. Microbiol. 1999, 86, 985–990. [Google Scholar] [CrossRef] [Green Version]
- Singla, A.K. Spreading of Semisolid Formulations: An Update. Available online: https://www.pharmtech.com/view/spreading-semisolid-formulations-update (accessed on 9 July 2022).
- Development and Evaluation of Anti-Acne Products from Terminalia Arjuna Bark—ScienceOpen. Available online: https://www.scienceopen.com/document?vid=b33654dd-01b9-4cd4-8eba-1d976418205b (accessed on 22 May 2022).
- Evans, A.; Kavanagh, K.A. Evaluation of metal-based antimicrobial compounds for the treatment of bacterial pathogens. J. Med. Microbiol. 2021, 70, 001363. [Google Scholar] [CrossRef]
- Beicu, R.; Alexa, E.; Obiștioiu, D.; Cocan, I.; Imbrea, F.; Pop, G.; Circioban, D.; Moisa, C.; Lupitu, A.; Copolovici, L.; et al. Antimicrobial Potential and Phytochemical Profile of Wild and Cultivated Populations of Thyme (Thymus sp.) Growing in Western Romania. Plants 2021, 10, 1833. [Google Scholar] [CrossRef]
- Vaidya, M.Y.; McBain, A.J.; Butler, J.A.; Banks, C.E.; Whitehead, K.A. Antimicrobial Efficacy and Synergy of Metal Ions against Enterococcus faecium, Klebsiella pneumoniae and Acinetobacter baumannii in Planktonic and Biofilm Phenotypes. Sci. Rep. 2017, 7, 5911. [Google Scholar] [CrossRef] [PubMed]
- Benhalima, L.; Amri, S.; Bensouilah, M.; Ouzrout, R. Antibacterial effect of copper sulfate against multidrug resistant nosocomial pathogens isolated from clinical samples. Pak. J. Med. Sci. 2019, 35, 1322–1328. [Google Scholar] [CrossRef] [PubMed] [Green Version]
Figure 1.
Spreadability values for F2 and fucidinTM at zero time, 1 month, and after 3 months at 25 °C and accelerated conditions (40 ± 2 °C/75% ± 5% RH).
Figure 1.
Spreadability values for F2 and fucidinTM at zero time, 1 month, and after 3 months at 25 °C and accelerated conditions (40 ± 2 °C/75% ± 5% RH).
Figure 2.
Viscosity of the F2 formula and fucidinTM at zero months and three months at 25 °C and accelerated conditions (40 ± 2 °C/75% ± 5% RH).
Figure 2.
Viscosity of the F2 formula and fucidinTM at zero months and three months at 25 °C and accelerated conditions (40 ± 2 °C/75% ± 5% RH).
Figure 3.
(A) (1): Cultured pathogen, (2): FucidinTM (control), and (3): F2 (sample) effect on E.coli isolate. (B) (1): Cultured pathogen, (2): FucidinTM (control), and (3): F2 (sample) effect on C. albicans isolate. (C) (1): Cultured pathogen, (2): FucidinTM (control), and (3): F2 (sample) effect on A. niger isolate. (D) (1): Cultured pathogen, (2): FucidinTM (control), and (3): F2 (sample) effect on P. aeruginosa isolate. (E) (1): Cultured pathogen, (2): Fucidin TM (control) and (3): F2 (sample) effect on S. aureus isolate.
Figure 3.
(A) (1): Cultured pathogen, (2): FucidinTM (control), and (3): F2 (sample) effect on E.coli isolate. (B) (1): Cultured pathogen, (2): FucidinTM (control), and (3): F2 (sample) effect on C. albicans isolate. (C) (1): Cultured pathogen, (2): FucidinTM (control), and (3): F2 (sample) effect on A. niger isolate. (D) (1): Cultured pathogen, (2): FucidinTM (control), and (3): F2 (sample) effect on P. aeruginosa isolate. (E) (1): Cultured pathogen, (2): Fucidin TM (control) and (3): F2 (sample) effect on S. aureus isolate.
Figure 4.
Antimicrobial susceptibility testing of S. aureus by disk diffusion method. (A): FRSA plate shows the resistance effect of different antimicrobial agents on S. aureus isolate to CT: ceftriaxone, FA: fusidic acid, GY: gentamycin, CP: ciprofloxacin, MR: meropenem. (B): FRSA plate F2 formula sensitive S. aureus shows the zone of inhibition more than 19 mm, T: at zero time, st: at the third month.
Figure 4.
Antimicrobial susceptibility testing of S. aureus by disk diffusion method. (A): FRSA plate shows the resistance effect of different antimicrobial agents on S. aureus isolate to CT: ceftriaxone, FA: fusidic acid, GY: gentamycin, CP: ciprofloxacin, MR: meropenem. (B): FRSA plate F2 formula sensitive S. aureus shows the zone of inhibition more than 19 mm, T: at zero time, st: at the third month.
Table 1.
Qualitative and quantitative compositions of 3 fusidic acid cream formulations.
Table 1.
Qualitative and quantitative compositions of 3 fusidic acid cream formulations.
| No. | Component | F1/g | F2/g | F3/g | Function |
|---|
| 1 | Fusidic acid | 2 | 2 | 2 | Active ingredient (API) |
| 2 | Zinc sulfate | 1 | 1 | 2 | Antibacterial, antiviral |
| 3 | Copper sulfate | 1 | 1.5 | 2 | Antibacterial, antifungal |
| 4 | Oleuropein | 0.2 | 0.4 | 0.6 | Antioxidant and preservative |
| 5 | Thyme oil | 0.1 mL | 0.1 mL | 0.1 mL | Antioxidant and preservative |
| 6 | Cetosteroyl alcohol | 7 | 7 | 7 | Emollient |
| 7 | Macrogol A6 | 1.5 | 1.5 | 1.5 | Emulsifying agent |
| 8 | Macrogol A25 | 1.5 | 1.5 | 1.5 | Emulsifying agent |
| 9 | Paraffin oil | 12 | 12 | 12 | Vehicle |
| 10 | Propylene glycol | 8 | 8 | 8 | Solvent |
| 11 | Purified water | 65.7 | 64.5 | 63.3 | Vehicle |
Table 2.
Evaluation of different topical formulations at 0, 1, and 3 months at accelerated conditions (40 ± 2 °C/75% ± 5% RH).
Table 2.
Evaluation of different topical formulations at 0, 1, and 3 months at accelerated conditions (40 ± 2 °C/75% ± 5% RH).
Characteristic
/Sample | Zone of Inhibition (mm) |
|---|
| F1 | F2 | F3 |
|---|
| S. aureus | E.coli | FRSA | S. aureus | E. coli | FRSA | S. aureus | E. coli | FRSA |
|---|
| Control (Fucidin TM) | 18.3 | 0 | 0 | 18.3 | 0 | 0 | 18.3 | 0 | 0 |
Aliquot Test (1)
zero time | 22.9 | 14.5 | 15.4 | 39.1 | 21.6 | 36.7 | 39.6 | 24.6 | 38.8 |
Aliquot Test (2)
one month | 22.4 | 14.3 | 15.2 | 36.8 | 21.4 | 34.5 | 38.2 | 23.8 | 37.6 |
Aliquot Test (3)
three months | 21.2 | 12.6 | 14.1 | 35.6 | 20.3 | 33.8 | 37.4 | 22.7 | 36.4 |
| Appearance | Light green | Light green | Bold blue–greenish |
| Spreadability | Good spreadability | Good spreadability | Thick spreadability |
Table 3.
Physicochemical evaluations for the F2 formula at zero time, one month, and after three months at 25 °C and accelerated conditions (40 ± 2 °C/75% ± 5% RH).
Table 3.
Physicochemical evaluations for the F2 formula at zero time, one month, and after three months at 25 °C and accelerated conditions (40 ± 2 °C/75% ± 5% RH).
| Time | Odor | Physical Appearance | Feel after Application | Texture | Color | Phase Separation | Homogeneity |
|---|
| Zero months | Light smell of thyme | Opaque | Moisture | Smooth | Light green | No | Homogenous |
| One month | Light smell of thyme | Opaque | Moisture | Smooth | Light green | No | Homogenous |
| Three months | Light smell of thyme | Opaque | Moisture | Smooth | Light green | No | Homogenous |
Table 4.
Percent fusidic acid and oleuropein content in formula F2 at zero time, one month, and three months at 25 °C and accelerated conditions (40 ± 2 °C/75% ± 5% RH) (n = 3).
Table 4.
Percent fusidic acid and oleuropein content in formula F2 at zero time, one month, and three months at 25 °C and accelerated conditions (40 ± 2 °C/75% ± 5% RH) (n = 3).
Assay of Agents
at Different Conditions | Zero Time | One Month | Three Months |
|---|
| Fusidic acid at 25 °C | 102 ± 0.11 | 99 ± 0.13 | 98 ± 0.13 |
| Fusidic acid at 40 °C | 101.4 ± 0.12 | 98.9 ± 0.10 | 97.8 ± 0.12 |
| Oleuropin at 25 °C | 98.6 ± 0.24 | 97.3 ± 0.26 | 95 ± 0.28 |
| Oleuropin at 40 °C | 98 ± 0.37 | 97 ± 0.42 | 95 ± 0.43 |
Table 5.
Percent zinc sulfate and copper sulfate content in formula F2 at zero time and 3 months at 25 °C and accelerated conditions (40 ± 2 °C/75% ± 5% RH) (n = 3).
Table 5.
Percent zinc sulfate and copper sulfate content in formula F2 at zero time and 3 months at 25 °C and accelerated conditions (40 ± 2 °C/75% ± 5% RH) (n = 3).
| Assay of Agents under Different Conditions | Zero Time | Three Months |
|---|
| Zinc Sulfate at 25 °C | 99.8 ± 0.82 | 96.2 ± 0.48 |
| Zinc Sulfate at 40 °C | 99.3 ± 0.73 | 95.4 ± 0.53 |
| Copper Sulfate at 25 °C | 98.7 ± 1.23 | 93.4 ± 1.60 |
| Copper Sulfate at 40 °C | 98.5 ± 1.28 | 92 ± 1.53 |
Table 6.
MICs of the F2 formula and active ingredients alone against the selected pathogens.
Table 6.
MICs of the F2 formula and active ingredients alone against the selected pathogens.
| |
C. albicans
|
E. coli
|
S. aureus
|
P. aeruginosa
|
|---|
| F2 | 85 | 14 | 10.5 | 150 |
| Fusidic acid | 1.7 | 0.28 | 0.21 | 3 |
| Copper sulfate |
1.3
|
0.21
|
0.16
|
2.25
|
| Zinc sulfate |
1.3
|
0.21
|
0.16
|
2.25
|
| Oleuropin |
0.3
|
0.06
|
0.04
|
0.6
|
| Thyme oil |
0.1
|
0.01
|
0.01
|
0.15
|
Table 7.
Physical parameters and assay results (as percentage) of formula condition at zero time and 3 months at 25 °C and accelerated condition (40 ± 2 °C/75% ± 5% RH) (n = 3).
Table 7.
Physical parameters and assay results (as percentage) of formula condition at zero time and 3 months at 25 °C and accelerated condition (40 ± 2 °C/75% ± 5% RH) (n = 3).
| Comparisons | Time | Precipitation | Appearance | Color | PH | Assay of Zinc Sulfate | Assay of Copper Sulfate | Assay of Oleuropine | Assay of |
|---|
| | | | | | | | | | Fusidic acid |
| Fusidic acid at 40 °C | 0 time | Negative | Uniform | Light green | 4.21 ± 0.02 | 99.3 ± 0.73 | 98.5 ± 1.25 | 98 ± 0.37 | 101.4 ± 0.12 |
| | 1 month | Negative | Uniform | Light green | 4.19 ± 0.04 | 96.8 ± 0.59 | 98.3 ± 1.21 | 97 ± 0.42 | 98.9 ± 0.10 |
| | 3 months | Negative | Uniform | Light green | 4.16 ± 0.03 | 95.4 ± 0.53 | 92 ± 1.53 | 95 ± 0.43 | 97.8 ± 0.12 |
| Fusidic acid at 25 °C | 0 time | Negative | Uniform | Light green | 4.23 ± 0.05 | 99.8 ± 0.82 | 98.7 ± 1.23 | 98.6 ± 0.42 | 102 ± 0.11 |
| | 1 month | Negative | Uniform | Light green | 4.22 ± 0.04 | 99.6 ± 0.79 | 96.4 ± 1.05 | 97.3 ± 0.26 | 99 ± 0.13 |
Table 8.
Antibacterial activity of the F2 formulation over a three-month period at 4 °C, 25 °C, and 40 °C (n = 3).
Table 8.
Antibacterial activity of the F2 formulation over a three-month period at 4 °C, 25 °C, and 40 °C (n = 3).
| | Period | Zone of Inhibition (mm) |
|---|
| Temperature (°C) |
|---|
| 4 °C | 25 °C | 40 °C |
|---|
| Plastic container | Zero time | - | 25.35 ± 0.21 | 24.8 ± 1.41 |
| One month | - | 24.55 ± 0.28 | 24.1 ± 1.10 |
| Two months | - | 23.85 ± 0.22 | - |
| Three months | 22.8 ± 0.07 | 22.38 ± 0.24 | 24.0 ± 1.30 |
| Publisher’s Note: MDPI stays neutral with regard to jurisdictional claims in published maps and institutional affiliations. |
© 2022 by the authors. Licensee MDPI, Basel, Switzerland. This article is an open access article distributed under the terms and conditions of the Creative Commons Attribution (CC BY) license (https://creativecommons.org/licenses/by/4.0/).